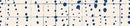
Rain Droplet

Largest Inventory of Panolam Edgebanding in America.
Same-Day Shipping
- 1 day FedEx & UPS
- Will-Call Available
- 5pm Local Cut-Off
- Custom Slitting
World-Class Service
- M-F Expert Support
- Quality Guaranteed
- Discount & Negotiated pricing
Frama-Tech Reviews & Ratings




















Panolam DG0045 Rain Droplet PVC Edge Banding Matches
Frama-Tech carries multiple PVC Edge Banding widths, thicknesses, finishes and textures for each Panolam Edge Bandinding match. You can also add a pre-glued backing to any of our items.
Widths: Most widths available for Panolam Edge Banding thanks to same-day slitting, most common are:
- 5/8" Rain Droplet PVC Edge Banding
- 7/8" Rain Droplet PVC Edgebanding
- 15/16" Rain Droplet PVC Edge Banding
- 1&5/16" Rain Droplet PVC Edgebanding
- 1&5/8" Rain Droplet PVC Edge Banding
- 1&3/4" Rain Droplet PVC Edgebanding
Thicknesses: For your convenience Frama-Tech carries all thicknesses of PVC Edge Banding:
- .5mm (Thin) PVC Edge Banding
- 1mm PVC Edge Banding Tape
- 1.5mm PVC Edge Banding
- 2mm PVC Edgebanding
- 3mm PVC Edge Banding Tape
Finishes: Frama-Tech carries all finishes for PVC Edgebanding to help you match perfectly to your laminate tops, here are some of the most popular Panolam PVC Edge Banding finishes we carry:
- Rain Droplet Gloss Finish Edgebanding
- Rain Droplet Natural Grain Finish Edge Banding
- Rain Droplet Matte Finish Edge Banding
- Rain Droplet Casual Rustic Finish Edgebanding
- Rain Droplet Timberline Finish Edgebanding
- Rain Droplet Woodgrain Finish Edge Banding
- Rain Droplet Linear Finish Edge Banding
- Rain Droplet Artisan Finish Edge Banding
- Rain Droplet Super Matte Finish Edgebanding
- Rain Droplet Soft Grain Finish Edgebanding
- Rain Droplet Pearl Essence Finish Edge Banding
- and many more
No Minimum Order Quantities: We custom produce and digitally print PVC Edge Banding with no minimums. If you cannot find what you need, call us!
Panolam DG0045 Rain Droplet ${ selected_design } Veneer Edgebanding